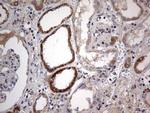
IGSF11 Antibody in Immunohistochemistry (Paraffin) (IHC (P))

Search
Invitrogen
IGSF11 Monoclonal Antibody (OTI2H1)
{{$productOrderCtrl.translations['antibody.pdp.commerceCard.promotion.promotions']}}
{{$productOrderCtrl.translations['antibody.pdp.commerceCard.promotion.viewpromo']}}
{{$productOrderCtrl.translations['antibody.pdp.commerceCard.promotion.promocode']}}: {{promo.promoCode}} {{promo.promoTitle}} {{promo.promoDescription}}. {{$productOrderCtrl.translations['antibody.pdp.commerceCard.promotion.learnmore']}}

Please note: We are reviewing Western blot images included in the antibody testing data in our catalog, including those provided by third parties. Unless expressly labeled or annotated as “raw-unedited”, Western blot images included in the antibody testing data in our catalog may have been edited, optimized or otherwise adjusted for presentation.
产品信息
MA5-26624
种属反应
已发表种属
宿主/亚型
分类
类型
克隆号
抗原
偶联物
形式
浓度
规格
纯化类型
保存液
内含物
保存条件
运输条件
RRID
靶标信息
Immunoglobulin superfamily member 11 (IGSF11) is a gene located on chromosome 3q13.3, encoding a transmembrane protein that belongs to the immunoglobulin superfamily. IGSF11 is known for its expression in the brain, where it plays a role in neuron-to-neuron adhesion and synaptic organization. The protein is involved in processes such as synapse formation and stabilization, impacting neural connectivity and signaling pathways. IGSF11 is also expressed in other tissues, including the gastrointestinal tract, where it can contribute to cell adhesion functions. Research has linked IGSF11 to cancer biology, as its expression is altered in various cancers, potentially influencing tumor cell adhesion and metastasis. Its role in modulating cell signaling pathways makes it an interesting target for therapeutic interventions in both neurological disorders and cancer. Current studies are focusing on its functional implications in synaptic plasticity and tumor progression, providing valuable insights into IGSF11's diverse biological roles.
仅用于科研。不用于诊断过程。未经明确授权不得转售。
生物信息学
蛋白别名: Brain and testis-specific immunoglobulin superfamily protein; Bt-IGSF; IgSF11; Immunoglobulin superfamily member 11; V-set and immunoglobulin domain-containing protein 3
基因别名: BTIGSF; CXADRL1; IGSF11; VSIG3
Entrez Gene ID: (Human) 152404




